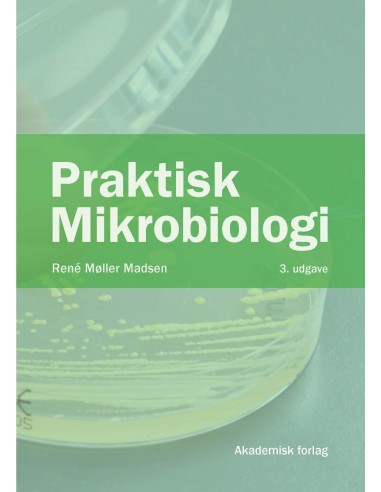
Praktisk mikrobiologi

Praktisk Mikrobiologi er en lærebog til undervisning af laboranter, procesteknologer og professionsbachelorer i ernæring og sundhed, men også andre kan få udbytte af at læse den.
Praktisk Mikrobiologi omhandler arbejdet i det mikrobiologiske laboratorium og hænger således sammen med Mikrobiologi ? Systematik ? Vækst ? Fødevarer, der tager sig af den teoretiske mikrobiologi.
Blandt bogens emner kan nævnes:
? Sikkerhed
? Præparater og mikroskopi
? Dyrkning af bakterier, morfologisk beskrivelse og undersøgelsesmetoder
? Substrater
? Rendyrkning og identifikation
? Svampeundersøgelse
? Kimtælling
? Desinfektion, sterilisation og hygiejnekontrol.
Praktisk Mikrobiologi er skrevet i et letlæseligt sprog - uden at gå på kompromis med fagligheden.
3. udgave af bogen er blevet fagligt opdateret og uddybet samt forsynet med nye illustrationer.
- Forfatter
- René Møller Madsen
- ISBN13
- 9788750061328
- ISBN10
- 8750061321
- Udgave /år
- 3 / 2022
- Forlag
- Akademisk Forlag
- Sidetal
- 192
- Indbinding
- Hæftet